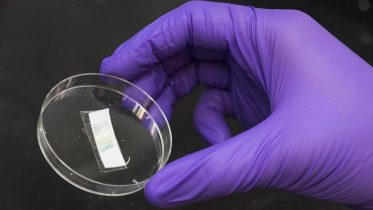
Materials Being Studied in the Korley Lab

Drawing inspiration from natural marvels to make new materials, UD researchers mimic the architecture of the bristle worm’s jaw system. A tiny bristle worm, wriggling...
The post Natural Marvels Lead to New Bio-Inspired Materials appeared first on SciTechDaily.
from SciTechDaily https://ift.tt/2MpBmJT
via IFTTT
EmoticonEmoticon